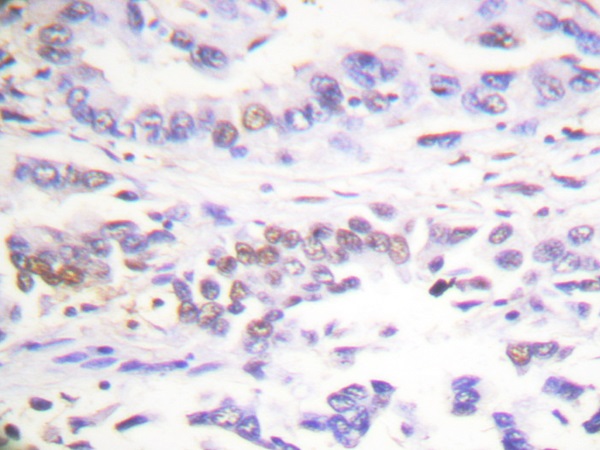

China
China Select Your Country Or Region
- United States
- Canada
- United Kingdom
- Australia
- China
- Germany
- France
- Japan
- Korea South
- Switzerland
- Algeria
- Argentina
- Austria
- Belgium
- Brazil
- Chile
- Croatia
- Czech Republic
- Denmark
- Finland
- Hong Kong, China
- Hungary
- India
- Iraq
- Ireland
- Israel
- Italy
- Lebanon
- Luxembourg
- Malaysia
- Mexico
- Morocco
- Netherlands
- New Zealand
- Norway
- Pakistan
- Peru
- Philippines
- Poland
- Portugal
- Qatar
- Russia
- Saudi Arabia
- Serbia
- Singapore
- Slovakia
- Slovenia
- South Africa
- Spain
- Sweden
- Taiwan, China
- Thailand
- Tunisia
- Turkey
- Ukraine
- Other Countries
Shopping Cart
Sign in \ Register